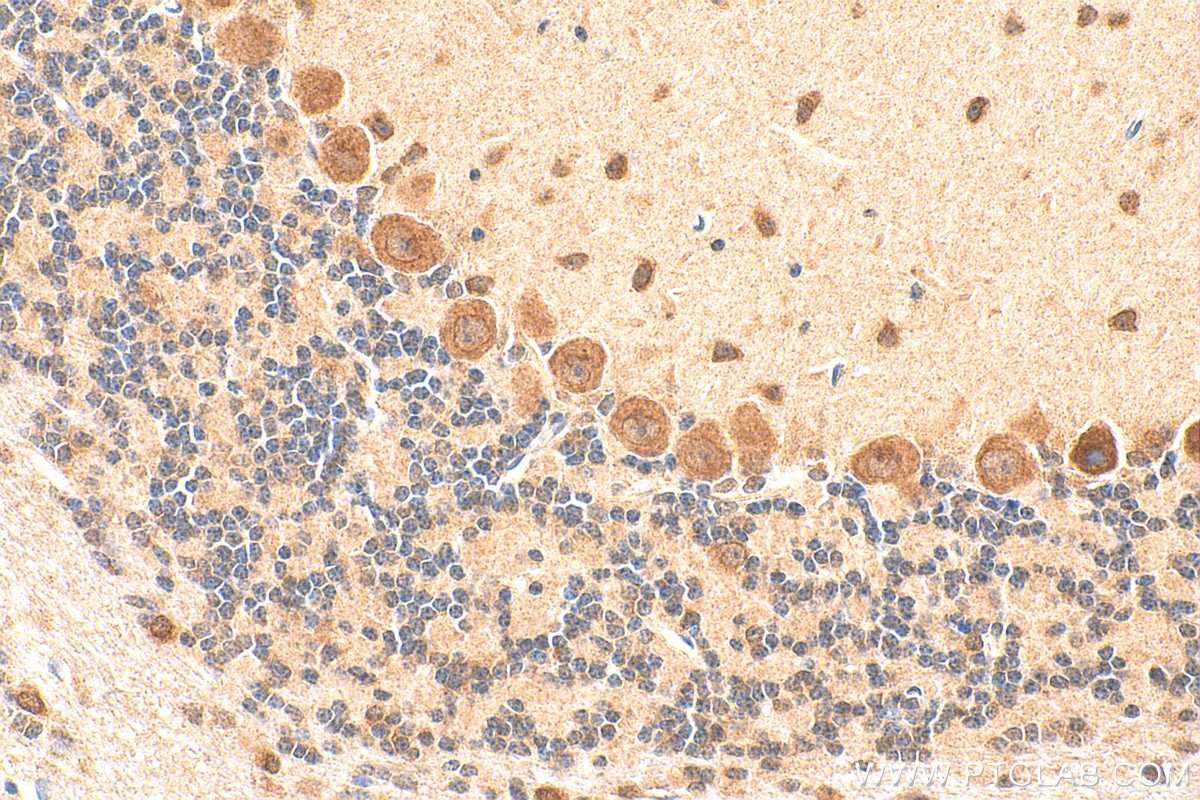
Immunohistochemistry (IHC) staining of mouse cerebellum tissue using BTG2 Polyclonal antibody (22339-1-AP)

Tested Applications
| Positive IHC detected in | mouse small intestine tissue, human kidney tissue, mouse cerebellum tissue Note: suggested antigen retrieval with TE buffer pH 9.0; (*) Alternatively, antigen retrieval may be performed with citrate buffer pH 6.0 |
| Positive IF/ICC detected in | Neuro-2a cells |
| Positive FC (Intra) detected in | SH-SY5Y cells, Neuro-2a cells |
Recommended dilution
| Application | Dilution |
|---|---|
| Immunohistochemistry (IHC) | IHC : 1:50-1:500 |
| Immunofluorescence (IF)/ICC | IF/ICC : 1:200-1:800 |
| Flow Cytometry (FC) (INTRA) | FC (INTRA) : 0.40 ug per 10^6 cells in a 100 µl suspension |
| It is recommended that this reagent should be titrated in each testing system to obtain optimal results. | |
| Sample-dependent, Check data in validation data gallery. | |
Published Applications
| KD/KO | See 3 publications below |
| WB | See 8 publications below |
| IHC | See 5 publications below |
| IF | See 1 publications below |
Product Information
22339-1-AP targets BTG2 in WB, IHC, IF/ICC, FC (Intra), ELISA applications and shows reactivity with human, mouse samples.
| Tested Reactivity | human, mouse |
| Cited Reactivity | human, mouse |
| Host / Isotype | Rabbit / IgG |
| Class | Polyclonal |
| Type | Antibody |
| Immunogen |
CatNo: Ag17819 Product name: Recombinant human BTG2 protein Source: e coli.-derived, PGEX-4T Tag: GST Domain: 1-50 aa of BC105949 Sequence: MSHGKGTDMLPEIAAAVGFLSSLLRTRGCVSEQRLKVFSGALQEALTEHY Predict reactive species |
| Full Name | BTG family, member 2 |
| Calculated Molecular Weight | 158 aa, 17 kDa |
| GenBank Accession Number | BC105949 |
| Gene Symbol | BTG2 |
| Gene ID (NCBI) | 7832 |
| RRID | AB_2879078 |
| Conjugate | Unconjugated |
| Form | Liquid |
| Purification Method | Antigen affinity purification |
| UNIPROT ID | P78543 |
| Storage Buffer | PBS with 0.02% sodium azide and 50% glycerol, pH 7.3. |
| Storage Conditions | Store at -20°C. Stable for one year after shipment. Aliquoting is unnecessary for -20oC storage. 20ul sizes contain 0.1% BSA. |
Background Information
Protein BTG2, the anti-proliferative human homolog of murine Pc3/Tis21, belongs to the BTG/Tob family. This family has structurally related proteins that appear to have anti-proliferative properties. It has been demonstrated that BTG2 is p53-inducible and is involved in cell cycle control and cellular response to DNA damage (PMID: 8944033). As a transcriptional co-regulator, BTG2 has been shown to interact with CAF1 and POP2, and works as a co-activator of ERa-mediated transcription via a CCR4-like complex (PMID: 18974182).
Protocols
| Product Specific Protocols | |
|---|---|
| FC protocol for BTG2 antibody 22339-1-AP | Download protocol |
| IF protocol for BTG2 antibody 22339-1-AP | Download protocol |
| IHC protocol for BTG2 antibody 22339-1-AP | Download protocol |
| Standard Protocols | |
|---|---|
| Click here to view our Standard Protocols |
Publications
| Species | Application | Title |
|---|---|---|
Front Oncol Transcriptomic Analyses Reveal B-Cell Translocation Gene 2 as a Potential Therapeutic Target in Ovarian Cancer.
| ||
FASEB J MicroRNA-409-3p/BTG2 signaling axis improves impaired angiogenesis and wound healing in obese mice | ||
ACS Chem Biol Epitranscriptomic N6-Methyladenosine Modification Is Required for Direct Lineage Reprogramming into Neurons. | ||
Front Mol Biosci Development and Validation of a 7-Gene Inflammatory Signature Forecasts Prognosis and Diverse Immune Landscape in Lung Adenocarcinoma. | ||
J Oncol lncRNA SNHG5 Modulates Endometrial Cancer Progression via the miR-25-3p/BTG2 Axis. | ||
Dig Dis Sci BTG2 Is Down-Regulated and Inhibits Cancer Stem Cell-Like Features of Side Population Cells in Hepatocellular Carcinoma. |
Reviews
The reviews below have been submitted by verified Proteintech customers who received an incentive for providing their feedback.
FH Tianyi (Verified Customer) (01-12-2024) | Antigen retrieval in TE buffer, incubated with AF488 at room temperature for 2 h.
|